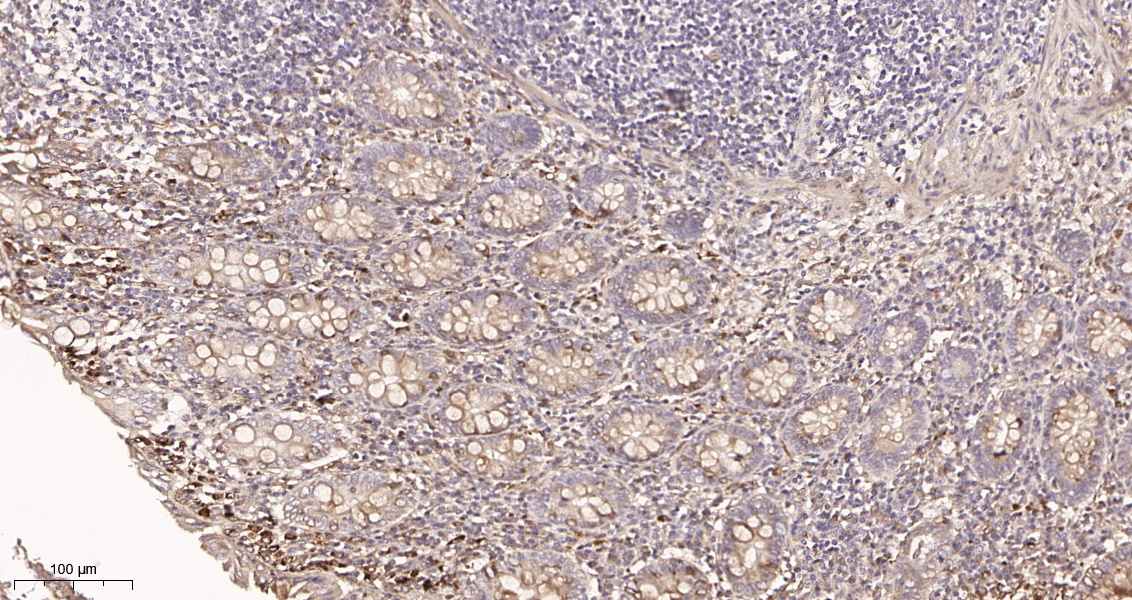

- 生化试剂
- ELISA检测
-
抗体蛋白
二抗生物素标记 过氧化物酶(HRP)标记 胶体金试剂 FITC荧光标记 RBITC荧光标记 二抗免疫血清 其它荧光标记二抗 藻红蛋白(PE)荧光标记 胶体金(Gold)标记 SAlexa Fluor荧光系列 碱性磷酸酶(AP)标记 别藻蓝蛋白(APC)荧光标记 其它标记 PE标记二抗 DyLight标记二抗 AU标记二抗 Biotin标记二抗 AMCA标记二抗 Texas Red标记二抗 TRITC标记二抗 HRP标记二抗 未标记二抗 Cy标记二抗 AbBox Fluor标记二抗内参抗体 小分子抗体抗体标记试剂盒细菌抗体蛋白病毒包装试剂杂交瘤融合筛选WB、IHC、ELISA相关试剂细胞培养试剂病原微生物抗原抗体假病毒抗体校准品其他抗原抗体标记的标签抗体病理级IHC抗体重组蛋白
- 细胞培养
- 实验耗材
- 仪器设备
- 生化试剂盒
- 小分子试剂
- 基质胶
-
斑马鱼产品
订货时间:周一至周五
订货Q Q:79688691
订货邮件:79688691@qq.com


 产品简介
产品简介-
产品货号IM68949
-
别名Arresten;BSVD;CO4A1_HUMAN;COL4A1;COL4A1 NC1 domain;COL4A2;COL4A3;COL4A4;COL4A5;collagen alpha-1(IV) chain;Collagen IV Alpha 1 Polypeptide;Collagen IV Alpha 2 Polypeptide;Collagen Of Basement Membrane Alpha 1 Chain;Collagen Of Basement Membrane Alpha 2 Chain;Collagen Type IV Alpha 1;collagen type IV alpha 1 chain;Collagen Type IV Alpha 2;Collagen Type IV Alpha 3;Collagen Type IV Alpha 4;Collagen Type IV Alpha 5;RatOR
-
产品名称Collagen IV (5S16) Rabbit Monoclonal Antibody
-
类别抗体产品
-
基因名称COL4A1
-
蛋白名称Collagen Type IV
-
ClonalityMonoclonal
-
推荐应用WB,IHC-P,IF-P,IF-F,IF-ICC,ELISA
-
反应种属Human
-
存储缓冲液PBS, 50% glycerol, 0.05% Proclin 300, 0.05%BSA
-
Human Gene ID1282
-
Human Swissprot No.P02462
-
稀释度IHC-P 1:200-1000, WB 1:1000-5000, IF-P/IF-F/IF-ICC 1:200-1000, ELISA 1:5000-20000
-
参考分子量200kDa
-
预测分子量160kDa
-
宿主Rabbit
-
同种型Monoclonal, rabbit, IgG, Kappa
-
背景介绍This gene encodes a type IV collagen alpha protein. Type IV collagen proteins are integral components of basement membranes. This gene shares a bidirectional promoter with a paralogous gene on the opposite strand. The protein consists of an amino-terminal 7S domain, a triple-helix forming collagenous domain, and a carboxy-terminal non-collagenous domain. It functions as part of a heterotrimer and interacts with other extracellular matrix components such as perlecans, proteoglycans, and laminins. In addition, proteolytic cleavage of the non-collagenous carboxy-terminal domain results in a biologically active fragment known as arresten, which has anti-angiogenic and tumor suppressor properties. Mutations in this gene cause porencephaly, cerebrovascular disease, and renal and muscular defects. Alternative splicing results in multiple transcript variants. [provided by RefSeq, Dec 2014].
-
功能disease:Defects in COL4A1 are a cause of brain small vessel disease with hemorrhage [MIM:607595]. Brain small vessel diseases underlie 20 to 30 percent of ischemic strokes and a larger proportion of intracerebral hemorrhages. Inheritance is autosomal dominant.,disease:Defects in COL4A1 are a cause of porencephaly type 1 [MIM:175780]; also known as encephaloclastic porencephaly. Porencephaly is a term used for any cavitation or cerebrospinal fluid-filled cyst in the brain. Porencephaly type 1 is usually unilateral and results from focal destructive lesions such as fetal vascular occlusion or birth trauma. Inheritance is autosomal dominant.,disease:Defects in COL4A1 are the cause of hereditary angiopathy with nephropathy, aneurysms, and muscle cramps (HANAC) [MIM:611773]. The clinical renal manifestations include hematuria and bilateral large cysts. Histologic analysis revealed complex basement membrane defects in kidney and skin. The systemic angiopathy appears to affect both small vessels and large arteries.,domain:Alpha chains of type IV collagen have a non-collagenous domain (NC1) at their C-terminus, frequent interruptions of the G-X-Y repeats in the long central triple-helical domain (which may cause flexibility in the triple helix), and a short N-terminal triple-helical 7S domain.,function:Type IV collagen is the major structural component of glomerular basement membranes (GBM), forming a 'chicken-wire' meshwork together with laminins, proteoglycans and entactin/nidogen. Potently inhibits endothelial cell proliferation and angiogenesis. Inhibits angiogenesis potentially via mechanisms involving cell surface proteoglycans and the alpha and beta integrins of endothelial cells.,PTM:Lysines at the third position of the tripeptide repeating unit (G-X-Y) are hydroxylated in all cases and bind carbohydrates.,PTM:Prolines at the third position of the tripeptide repeating unit (G-X-Y) are hydroxylated in some or all of the chains.,PTM:The trimeric structure of the NC1 domains may be stabilized by covalent bonds between Lys and Met residues.,PTM:Type IV collagens contain numerous cysteine residues which are involved in inter- and intramolecular disulfide bonding. 12 of these, located in the NC1 domain, are conserved in all known type IV collagens.,similarity:Belongs to the type IV collagen family.,similarity:Contains 1 collagen IV NC1 (C-terminal non-collagenous) domain.,subunit:There are six type IV collagen isoforms, alpha 1(IV)-alpha 6(IV), each of which can form a triple helix structure with 2 other chains to generate type IV collagen network.,tissue specificity:Highly expressed in placenta.
-
纯化Protein A
 储存与保存
储存与保存1.保存:-20℃
2.有效期:1年
 注意事项
注意事项1.我司生产的生化试剂如无特殊标注,基本为非无菌包装,若用于细胞实验,请提前做好预处理。需低温保存的产品,一旦配成溶液,请分装保存,避免反复冻融造成的产品失效。
2.本产品仅供科研使用。请勿用于医药、临床诊断或治疗,食品及化妆品等用途。请勿存放于普通住宅区。
3.为了您的安全和健康,请穿好实验服并佩戴一次性手套和口罩操作。
4.实验结果可由多种因素影响,相关处理只限于产品本身,不涉及其他赔偿。
备注:由于产品信息可能会有优化升级,请以实际收货标签信息为准。
-
 iNOS (7T6) Rabbit Monoclonal Antibody¥1300.00货号:IM72030
iNOS (7T6) Rabbit Monoclonal Antibody¥1300.00货号:IM72030 -
 NF-κB p65 (Phospho Ser536) (14B13) Rabbit Monoclonal Antibody¥1300.00货号:IM72029
NF-κB p65 (Phospho Ser536) (14B13) Rabbit Monoclonal Antibody¥1300.00货号:IM72029 -
 PI3-Kinase p110α (11A15) Rabbit Monoclonal Antibody¥1300.00货号:IM72028
PI3-Kinase p110α (11A15) Rabbit Monoclonal Antibody¥1300.00货号:IM72028 -
 FAP (6L4) Rabbit Monoclonal Antibody¥1300.00货号:IM72027
FAP (6L4) Rabbit Monoclonal Antibody¥1300.00货号:IM72027 -
 KANSL1L Rabbit polyclonal antibody¥1400.00货号:IM72021
KANSL1L Rabbit polyclonal antibody¥1400.00货号:IM72021